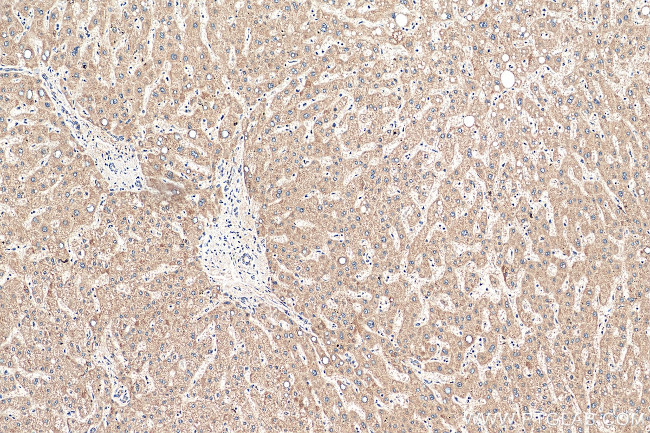
CFHR3 Antibody in Immunohistochemistry (Paraffin) (IHC (P))

Search
Proteintech
CFHR3 Polyclonal Antibody
{{$productOrderCtrl.translations['antibody.pdp.commerceCard.promotion.promotions']}}
{{$productOrderCtrl.translations['antibody.pdp.commerceCard.promotion.viewpromo']}}
{{$productOrderCtrl.translations['antibody.pdp.commerceCard.promotion.promocode']}}: {{promo.promoCode}} {{promo.promoTitle}} {{promo.promoDescription}}. {{$productOrderCtrl.translations['antibody.pdp.commerceCard.promotion.learnmore']}}
产品信息
16583-1-AP
种属反应
已发表种属
宿主/亚型
分类
类型
抗原
偶联物
形式
浓度
规格
纯化类型
保存液
内含物
保存条件
运输条件
产品详细信息
Immunogen sequence: MLLLINVIL TLWVSCANGQ VKPCDFPDIK HGGLFHENMR RPYFPVAVGK YYSYYCDEHF ETPSGSYWDY IHCTQNGWSP AVPCLRKCYF PYLENGYNQN YGRKFVQGNS TEVACHPGYG LPKAQTTVTC TEKGWSPTPR CIRVRTCSKS DIEIENGFIS ESSSIYILNK EIQYKCKPGY ATADGNSSGS ITCLQNGWSA QPICINSSEK CGPPPPISNG DTTSFLLKVY VPQSRVEYQC QPYYELQGSN YVTCSNGEWS EPPRCIHPCI ITEENMNKNN IKLKGRSDRK YYAKTGDTIE FMCKLGYNAN TSILSFQAVC REGIVEYPRC E (1-330 aa encoded by BC058009)
靶标信息
The protein encoded by this gene is a secreted protein, which belongs to the complement factor H-related protein family. It binds to heparin, and may be involved in complement regulation. Mutations in this gene are associated with decreased risk of age-related macular degeneration, and with an increased risk of atypical hemolytic-uremic syndrome. Alternatively spliced transcript variants encoding different isoforms have been found for this gene.
仅用于科研。不用于诊断过程。未经明确授权不得转售。
生物信息学
蛋白别名: Complement factor H-related protein 3; DOWN16; FHR-3; H factor-like 4; H factor-like protein 3; unnamed protein product
基因别名: CFHL3; CFHR3; DOWN16; EG624286; FHR-3; FHR3; HLF4
UniProt ID: (Human) Q02985
Entrez Gene ID: (Human) 10878, (Mouse) 624286